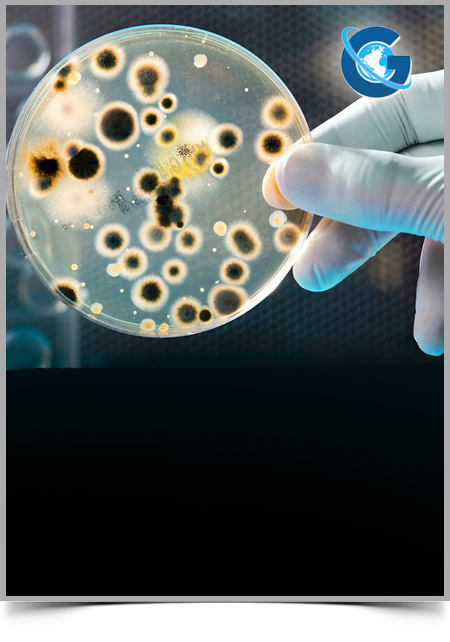
Assessment of Genetics Mutation PRNP Gene induction Prion Disease, in Tabriz, Iran

Journal of Microbiology and Genetics
ISSN: 2574-7371
Impact Factor: 2.01

Differential expression analysis of HEG1 and MUC20 genes in multiple tissues of Large White piglets with resistance and susceptible phenotypes to ETEC-F4ac diarrhea
Serafino M. A. Augustino,, Qinglei Xu, Martin. B. R. Sebit, Qingyao Zhao, Erneo B. Ochi, Ying Yu
Journal of Microbiology and Genetics
Determination of Tigecycline and Colistin Susceptibility among Carbapenemase Producing Isolates of Gram Negative Bacteria in a Tertiary Care Hospital
Justine Auxilia Irene Chinnappan*, Lakshmipriya N, Umadevi U, Thasneem Banu S
Journal of Microbiology and Genetics

Cytokines as Effective Elements of the Avian Immune System
Hanan Al-Khalaifah*, A. Al-Nasser
Journal of Microbiology and Genetics
Deletion of Lipoprotein Gene rlpA Causes Supersensitivity of Escherichia colito Several Antibiotics
Hideaki Kamata*, Michio Matsuhashi
Journal of Microbiology and Genetics
Duration of Hypoxemia in Pneumocystis Jiroveciii Pneumonia
Gabriel M. Aisenberg*, Daniel Ocazionez-Trujillo, Roberto C. Arduino
Journal of Microbiology and Genetics
Review: Biotechnology Applications of Microalgae in the Context of EU “Blue Growth” Initiatives
Rafael Carrasco, Carlos Fajardo, Palmira Guarnizo, Roberto A. Vallejo, Francisco J. Fernandez-Acero*
Journal of Microbiology and Genetics
Pathological Changes in the Nervous System of Horse Naturally Affected By Dourine in Arsi-Bale Highlands, Ethiopia
Melke Meseret, Hagos Ashenafi, Solomon Tsegaye
Journal of Microbiology and Genetics